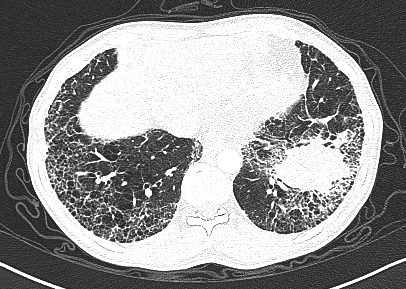
这份肺纤维化肺癌67读片秘籍请收好

纤维化肺

肺纤维化
图片尺寸536x804
什么是肺纤维化?
图片尺寸1685x1280
肺纤维化
图片尺寸987x1428
肺纤维化
图片尺寸792x528
医学生笔记 #慢阻肺 #间质性肺纤维化 #胸部ct #呼吸科
图片尺寸1080x1452
肺纤维化
图片尺寸1800x1283
肺纤维化
图片尺寸650x564
特发性肺纤维化诊疗指南更新重点都在这里
图片尺寸1020x1065
中医治疗肺纤维化有什么优势
图片尺寸640x447
海外直订医药图书idiopathic pulmonary fibrosis 特发性肺纤维化
图片尺寸800x800
肺纤维化
图片尺寸2048x1582
肺纤维化能活半年到十年不等的时间,具体存活时间需要根据患者病情
图片尺寸1065x1280
肺纤维化
图片尺寸792x528
首例新冠危重症患者病理报告:全肺表面呈古铜色,大量肺间质纤维化
图片尺寸650x530
特发性肺纤维化诊疗指南更新重点都在这里
图片尺寸974x998
肺间质纤维化影像学表现
图片尺寸640x479
肺纤维化
图片尺寸500x375
这份肺纤维化肺癌67读片秘籍请收好
图片尺寸406x289
基于深度学习的肺纤维化疾病高分辨率ct自动分类
图片尺寸631x423
指南共识进展性肺纤维化表现的结缔组织病相关间质性肺疾病患者临床
图片尺寸1057x508